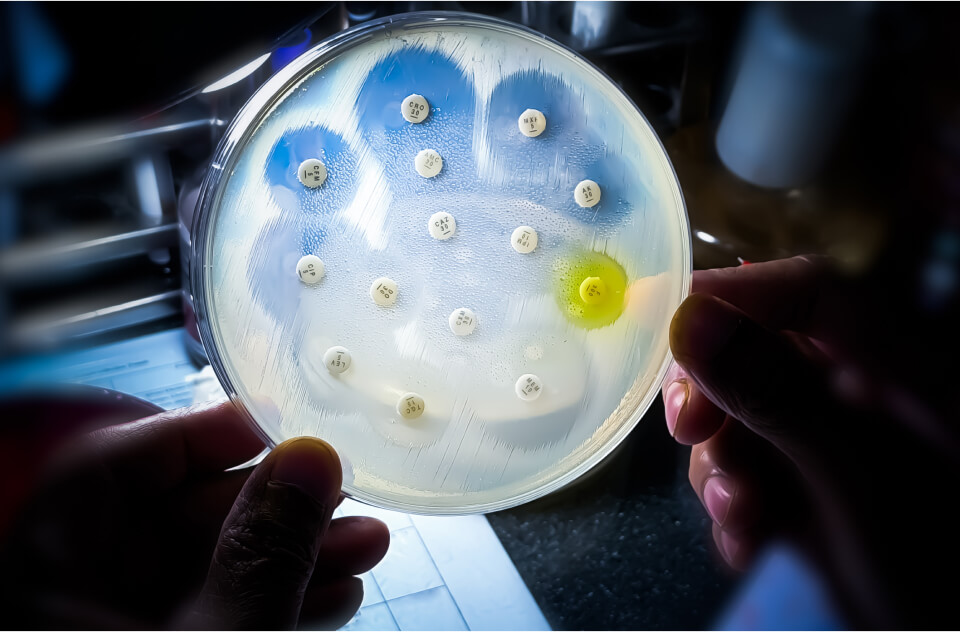
Expanding the Modality Landscape Beyond Traditional Antibiotics

Antimicrobial resistance (AMR) is a leading global public health challenge. Unchecked, it is projected to be responsible for or contribute to nearly 10 million deaths per year by 2050.
disAMR, the next evolution of AMR Insights, is working tirelessly to align the science, capital, and policy needed to reshape market dynamics and create incentives to develop a range of solutions that address the AMR crisis.

Uniting the Global AMR Collective
disAMR will bring together organizations and individuals committed to tackling AMR. While a fully functioning website will launch later this year, we invite you to join us on this journey and share your valued insights and perspectives.
disAMR's Vision
Discover the vision, follow our progress, and contribute your ideas as the disAMR team and thought leaders across the global AMR landscape solidify projects, products, and initiatives to diminish AMR's threat.
Join the Fight
Reducing the risks of AMR requires coordinated efforts among stakeholders worldwide. No matter who you are or what your areas of expertise are, learn how to get involved to help address this critical issue.
The Latest from the disAMR Knowledge Hub

When the Cure Stops Working: Antimicrobial Resistance and the Fragile Future of Modern Medicine
25 February 2026

How Antimicrobials Work: Mechanisms of Action, Strengths, and Vulnerabilities
25 February 2026

The Antimicrobial Supply Chain:
Why Therapeutic Innovation Alone Won’t Solve AMR
25 February 2026
Help Spread the Word
If you are an organization, professional, or individual passionate about countering the threat of AMR, we invite you to help us spread the word. Within disAMR’s Media Resources repository, you’ll find materials for social media posting, logos, images, information about disAMR, and more.

Stay Updated
Stay connected so that you don't miss the latest AMR insights and updates.